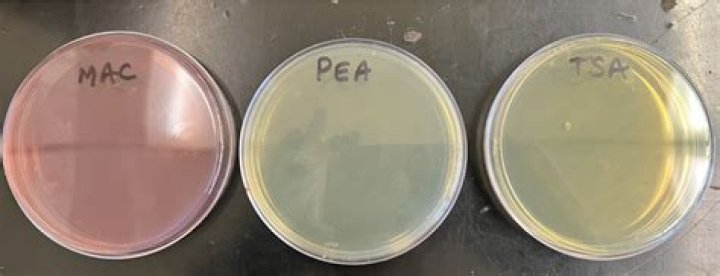

What type of medium is TSA
TSA is the medium specified as Soybean-Casein-Digest Agar Medium by the United States Pharmacopeia (USP) for the total aerobic count portion of microbial limit testing procedures. The medium is also used for maintenance of stock cultures, plate counts and isolation of organisms from a variety of specimen types.
What kind of media is TSA?
Tryptic Soy Agar or Trypticase Soy Agar, often abbreviated as TSA, is a general purpose, non-selective agar media that supports the growth of a wide-range of microorganisms. TSA can be used for a variety of applications including culture storage, enumeration, and isolation of microorganisms.
What kind of medium is tryptic soy agar?
Tryptic Soy Agar is a general purpose culture medium for cultivation, isolation of fastidious or nonfastidious microorganisms or for maintenance of stock culture.
What type of media is TSA and why?
Trypticase soy agar or tryptone soya agar (TSA) and Trypticase soy broth or tryptone soya broth (TSB) with agar are growth media for the culturing of bacteria. They are general-purpose, nonselective media providing enough nutrients to allow for a wide variety of microorganisms to grow.Is TSA selective or differential?
Tryptic Soy Agar (TSA): a general purpose, non-selective, non-differential, supportive medium that supports growth of all microorganisms that do not require special nutrients.
What is a TSA agar plate?
Tryptic Soy Agar (TSA) is a general purpose plating medium used for the isolation, cultivation, and maintenance of a variety of fastidious and non- fastidious microorganisms. … TSA is recognized and recommended by numerous agencies around the world.
Is TSA a complex medium?
Tryptic Soy Agar (TSA) is a complex medium for cultivation and isolation of a wide range of bacteria, yeasts and molds. This medium contains several peptones, providing amino acids and polypeptides to ensure growth of a variety of microorganisms. Sodium chloride maintains osmotic equilibrium in the medium.
Is TSA enriched media?
Enriched Tryptic Soy Agar (ETSA) is an enriched, non-selective, and differential medium intended for the isolation, quantitation, and partial identification of many fastidious and non-fastidious microorganisms.What type of agar is TSA quizlet?
An example is Trypticase Soy Agar (TSA). Most organisms can grow on this due to abundance of growth factors and vitamins in the medium.
Which microbes will grow on the TSA media?Tryptic Soy Agar supports the growth of a wide variety of organisms including fastidious and non- fastidious such as Neisseria, Listeria, and Brucella, etc. Tryptone Soya Broth with added dextrose, sodium chloride, and agar is recommended for the cultivation of Salmonella Typhi.
Article first time published onWhat is the difference between TSA and TSB?
Tryptic Soy Agar (TSA) and Tryptic Soy Broth (TSB), for example, have the same nutrient profile and similar ingredients, but TSA is a solid and TSB is a liquid. For conducting passive air sampling, a solid TSA plate is easier to handle and leave out in the hood during compounding.
What type of medium is MacConkey Agar?
MacConkey agar (MAC) is a bacterial culture medium named after bacteriologist Alfred T. MacConkey (1861-1931). MacConkey agar is a selective and differentiating agar that only grows gram-negative bacterial species; it can further differentiate the gram-negative organisms based on their lactose metabolism.
What is a complex medium?
Complex media are rich in nutrients that contain water soluble extracts of plant or animal tissue (e.g., enzymatically digested animal proteins such as peptone and tryptone). Usually a sugar, often glucose, is added to serve as the main carbon and energy source.
What is selective medium?
Selective media are used for the growth of only selected microorganisms. For example, if a microorganism is resistant to a certain antibiotic, such as ampicillin or tetracycline, then that antibiotic can be added to the medium in order to prevent other cells, which do not possess the resistance, from growing.
What ingredient makes this medium selective?
This medium is both selective and differential. The selective ingredients are the bile salts and the dye, crystal violet which inhibit the growth of Gram-positive bacteria.
Why are TSA plates used?
Tryptic soy agar (TSA) is mainly used as an initial growth medium for the purposes of observing colony morphology, developing a pure culture, and achieving sufficient growth for further biochemical testing and culture storage. TSA slants are being used to store and ship bacterial cultures.
Is TSA a complex medium or is it chemically defined?
Glucose Salts Agar (GSA): is a simple, defined medium. Only organisms that can make all their cellular components from glucose and inorganic salts are able to grow on this medium. Tryptic Soy Agar (TSA): is a rich, undefined medium containing products of an enzymatic digest of protein and soy product.
Is TSA defined or complex?
It is a complex, general purpose medium that is routinely used to grow certain pathogenic bacteria, which tend to have high nutritional requirements (i.e., they are fastidious). Its agar counterpart is tryptic soy agar (TSA).
Is TSA complex or chemically defined?
TSA. Trypticase soy agar. Chemically undefined (complex) media, digested soy product and protein.
What bacteria is red on TSA plate?
At room temperature, Serratia marcescens grew as bright, glossy red colonies on the TSA plate.
Is nutrient agar selective or differential?
1. Observe the growth and appearance of colonies on all plates. Notice that nutrient agar is neither a selective nor differential medium.
What does TSA test for?
Safety, Search, and Seizure. As CNN explained, the Transportation Security Administration randomly swabs passengers’ hands at checkpoints and airport gates to test them for traces of explosives. This was an expansion from simply swabbing luggage and other items.
Does resistant E coli grow on TSA?
coli counts on half-strength TSA remained unchanged between 8 hours and 6 days. When counted on EMB agar, the abundance of the antibiotic-resistant strain ofE. coli and a strain not selected for resistance increased in solutions containing phosphate and amino acids but declined in the presence of high densities ofR.
Is chocolate agar selective or differential?
Chocolate Agar is an enriched general- purpose medium that supports the growth of most fastidious and non-fastidious organisms. Because it is a non-selective medium, resident flora from clinical specimens may overgrow potential fastidious pathogens, such as Neisseria species.
Do sensitive E coli cells grow on TSA?
coli O157:H7 cells recovered on TSA; pH did not significantly affect the viability of cells. Recovery was significantly reduced on MSMA when cells were heated in TSB with reduced pH or a(w) for an increased length of time. … TSB (a(w), 0.99) at pH 6.0 or 5.4 supported growth of E.
What is agar CNA?
CNA is a selective, differential agar medium used for isolation of gram positive bacteria in a variety of specimen types. It is used frequently in clinical laboratories.
What is a non-selective medium?
Non-selective media are intended to cultivate microorganisms in order to multiply them. It is a simple culture medium without a selection agent that will allow the growth of microorganisms in an undifferentiated way. … They contain all the elements that most microorganisms need to grow.
Is eosin methylene blue agar selective or differential?
Eosin methylene blue agar (EMB) is a selective and differential medium used to isolate fecal coliforms. Eosin Y and methylene blue are pH indicator dyes which combine to form a dark purple precipitate at low pH; they also serve to inhibit the growth of most Gram positive organisms.
Does Salmonella grow on TSA?
Xylose lysine decarboxylase (XLD) medium, a selective plating medium, can inhibit heat-injured Salmonella typhimurium from growing, whereas tryptic soy agar (TSA), a nonselective medium, does not. To facilitate recovery of heat-injured S.
How many types of colonies are formed in the TSA agar?
Two different types of bacterial colonies on an agar plate. Using microbiology terms, describe fully the colonial morphology of the two colonies shown above. A full description will include texture, transparency, color, and form (size, overall shape, margin, and elevation).
What is a common medium used to culture microorganisms?
The most common growth media for microorganisms are nutrient broths (liquid nutrient medium) or lysogeny broth medium. Liquid media are often mixed with agar and poured via a sterile media dispenser into Petri dishes to solidify. These agar plates provide a solid medium on which microbes may be cultured.



